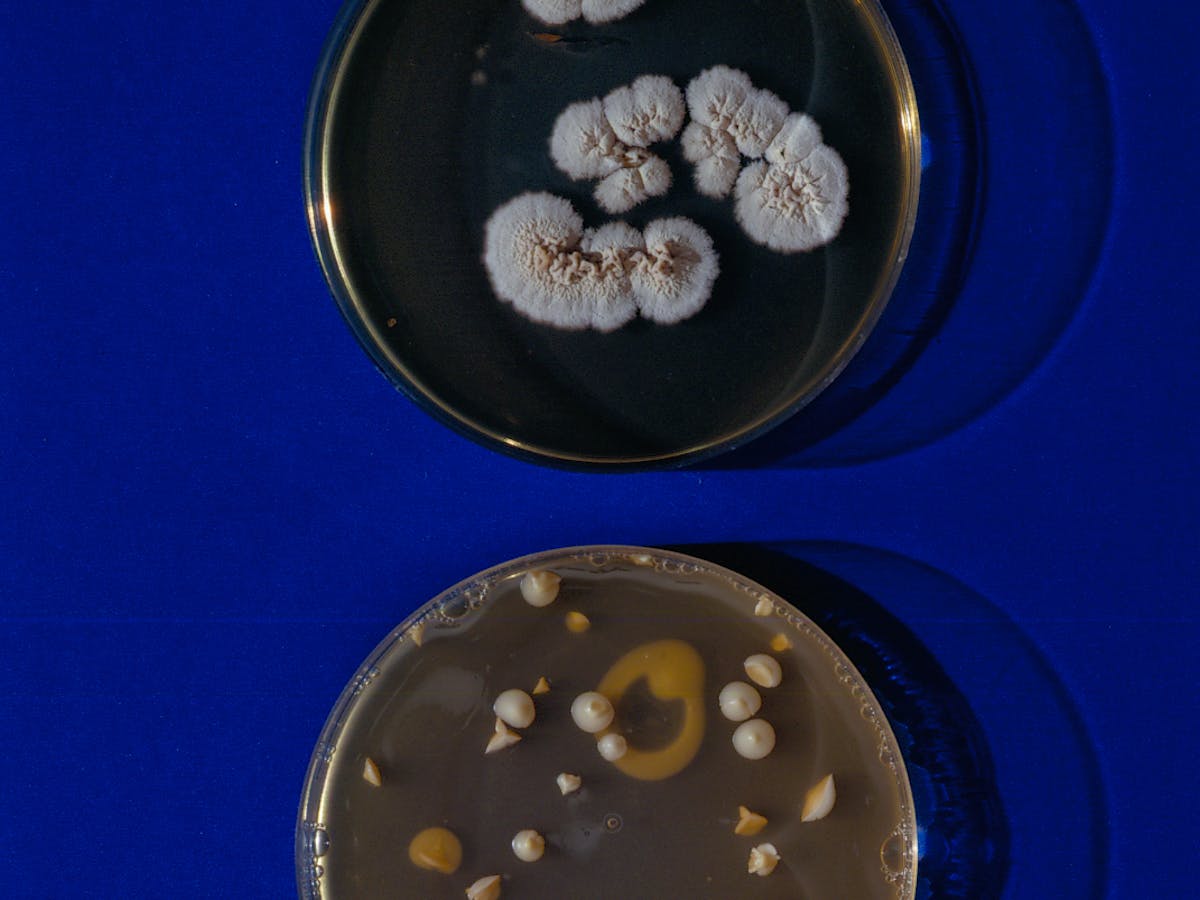
content-image

Science has come a long way in the past two decades. With increased specialization, collaboration has also become more important.
Published on 22/11/2022
When Novartis was founded in 1996, the company’s creation out of the merger between Sandoz and Ciba-Geigy was hailed as an industrial milestone. Not only was the new company equipped with what was then a whopping 2 billion dollars in annual funds to drive drug research and development, its ambition was to stay at the forefront of scientific discovery and experiment with the most cutting-edge technologies at the time.
This included an early gene therapy to treat brain cancer and a xenotransplantation therapy, which was all the rage at the time and attracted press coverage from all over the world. The medical need was clearly there. To this day, there is an organ shortage when it comes to treating people that need a heart, lung or liver transplant. Using animal replacement organs would fill the gap.
While hopes were high, Chairman Joerg Reinhardt, who led the preclinical efforts at the time, tried to keep a realistic perspective on the chances of success, repeatedly pointing to the many unsolved challenges surrounding the transplantation of organs from one species to another. Likewise, Paul Herrling, who oversaw the research efforts of Novartis back then, dampened high expectations by saying that the company’s gene therapy efforts in treating glioblastoma were only at a very early stage.
Both efforts reached a dead end around the millennium. And it would take Novartis more than a decade before it would once again venture into gene therapy. The technologies were not ready for prime time back then, as too many fundamental scientific questions were still unresolved. Even to this day, although xenotransplants have made huge leaps forward and could enter clinical trials in the United States, they are still the stuff of futuristic dreams.
Despite these setbacks, which are part and parcel of the drug discovery process where 1 in 10000 new molecules eventually makes it to market, Novartis has never stopped exploring the cutting edge of science. Over the past two decades, the company has also consistently increased its research and development efforts, which today have reached some 9 billion US dollars annually.
Besides two major research hubs with some 6000 scientists in Cambridge and Basel, more than 10000 healthcare specialists in drug development are working on more than 150 clinical trials that encompass small- and large-molecule drugs, as well as gene and radioligand therapies, which have matured to a stage to be part of everyday clinical practice.
Since the arrival of Vas Narasimhan as Chief Executive Officer of Novartis, the company has broadened its technological reach to include novel gene therapies, cutting-edge nuclear medicine therapies and gene-silencing RNA approaches, which allow the treatment of diseases that were deemed out of reach of medicine just a few years back.
The company also had the courage to pursue novel disease targets that were considered undruggable in the past – always driven by a sense of scientific curiosity and the company’s purpose to improve and extend people’s lives. While failures were not uncommon in this attempt to change the practice of medicine, the urge to explore new ground and make a difference for patients has always been present.
For Novartis CEO Vas Narasimhan, this attitude will remain the company’s north star as he is convinced that “the future of medicine is here.” As he explains in the following essay, prospects to develop breakthrough therapies have never been greater at any other point in history. But neither have the challenges that medical and healthcare systems face. To overcome these challenges, Narasimhan prescribes a mixture of scientific, cultural and organizational remedies that are designed not only to push science forward, but also to get these medicines to as many patients as possible. It is a future that needs to be embraced.
We are at a turning point in the history of medicine
Science and technology are advancing at an unprecedented pace, and we have more knowledge at our fingertips than ever before. They are leading to breakthroughs in healthcare and medicine – and only in stepping back and considering the full arc of human progress in medicine can we truly recognize the extraordinary moment we are in.
These developments come at an important time, as meeting the opportunity to improve human life remains more necessary than ever. Even today, the vast spectrum of disease remains largely untreated. We are currently only able to significantly impact less than 10 percent of the 7000 to 8000 diseases known to affect humans.
As science advances, so will the biopharmaceutical industry and the medicines we create – and if we innovate and work across sectors in the right ways, we will translate that science into lasting, meaningful progress.
A 120-year innovation arc
The modern biopharmaceutical industry came to the fore in the late 1800s, and for the better part of a century, we primarily used chemicals to modulate functions in the body. At the beginning, we still didn’t fully understand the inner workings of cells or how diseases progressed.
As science and industry advanced, we learned more about the biology of health and disease, and created better, safer, more effective chemicals known today as small-molecule drugs.
Then, roughly 40 years ago, science led to a breakthrough. Protein therapies and monoclonal antibodies allowed us to modulate the activity of specific proteins – a sea change in our ability to go after the exact molecular drivers of disease.
These were and still are central contributors to improving life expectancy and quality of life, and alongside traditional vaccines, they were essentially the only kinds of medicine produced by the industry in its first 120 years.
Scientific progress at a historic pace
Today, we are probing human biology at its most fundamental levels, and coupled with technological advancements, we have created entirely new, unprecedented ways to intervene in disease. In just the past few years, multiple new types of treatment– a new generation of medicines – have been approved and are reaching patients, including RNA therapies, RNA vaccines, cell therapies, gene therapies and radioligand therapies.
Juxtaposed against early advances in science, the pace of innovation is dramatically accelerating. Just a few years after Emmanuelle Charpentier and Jennifer Doudna won the Nobel Prize in Chemistry for their work on CRISPR/Cas9, a method to edit DNA, we are exploring DNA and RNA gene and base editing to make new medicines. It is a breakneck pace and could shape an exciting future in which we could have an even greater impact on patients’ lives.